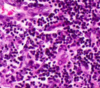
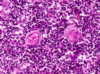

לימפה Flashcards
(61 cards)
מהו איבר לימפטי ראשוני?
מייצר לימפוציטים
(האיברים הם מח עצם, תימוס)
מהם איברים לימפטיים שניוניים?
שקדים, טחול, קשרי לימפה
מה ההבדל בין איברים לימפטיים ראשוניים לשיוניים?
בראשוניים יש היווצרות של לימפוציטים,
בשניוניים הלימפוציטים עוברים דיפרדניצאציה ופרוליפרציה,
מקום העבודה המרכזי של הלימפוציטים הוא באיברים השניוניים - שקדים טחול וקשרי לימפה
B מהם לימפוציטים מסוג ?
Bone marrow
מח עצם
(מיוצרים שם)
T מהם לימפוציטים מסוג?
תימוס
בתימוס יש יצירה של לימפוציטים מסוג T
לפי מה רקמה לימפטית מוגדרת?
כמות התאים הלימפוציטים שבה
רפה- ריכוז נמוך
צפופה- ריכוז גדול
נודולרית- כמו צפופה רק עגולה
מה מאפיין מבנה של איברים לימפטיים?
- רקמת חיבור- כמעט תמיד
- לימפוציטים- תמיד
- פיברובלסטים, מייצרים רת הסיבים הרטיקולריים של רקמת החיבור הלימפטית באיבר
(reticular cells נקראים גם)
למה כלים לימפטיים דומים יותר- עורקים או ורידים?
ורידים, מצופים באנדותל ויש להם שסתומים.
מחברים בין קשרי לימפה
מה התפקיד של הכלים הלימפטיים?
לחבר בין קשרי/ בלוטות לימפה
Lymph nodes
מה ההבדל בין קשר לימפה לזקיק לימפה?
השם המעצבן שלהם
Lymph nodes- קשרי לימפה/ בלוטות לימפה
Lymph nodule - קשרית (זקיק) לימפה
Lymphatic nodules מהן ה
רקמה לימפטית- קשריות/ זקיקי לימפה.
רקמהה לימפטית נודולרית
נמצאים כמעט בכל האיברים הלימפטיים (חוץ מהתימוס)
מלאים בריכוז גבוה של לימפוציטים מסוג B
B איפה נמצא הריכוז הגדול ביותר של לימפוציטים מסוג ?
קשריות/ זקיקי לימפה
Lymphatic nodules
באיזה איבר אין זקיקי לימפה?
תימוס
(הגיוני- כי בתימוס נוצרים לימפוציטים מסוג T
ובזקיקי לימפה יש לימפוציטים מסוג B)
MALT מה זה?
mucosa Associated Lymphatic Tissue
Noudels (זקיקי)
נמצאים באיזורים חלולים בגוף שלנו שיש בהם שכבת מוקוזה
(למשל, מערכת עיגול, מערכת הנשימה, השתן ועוד)
איך קוראים ל-
Noudels (זקיקי)
שנמצאים באיזורים חלולים בגוף שלנו שיש בהם שכבת מוקוזה
(למשל, מערכת עיגול, מערכת הנשימה, השתן ועוד)
MALT
mucosa Associated Lymphatic Tissue
מה מסומן במס 2 בתמונה?

Germinal center
Lhymph nodule בתוך ה
מסומן במס 2 בתמונה
המוקד בו לימפוציטים מסוג B
מתחילים את תהליך הדיפרנציאציה והפרוליפרציה שלהם

Lympth nodule איך קוראים למרכז הבהיר ב
Germinal center
מסומן במס 2 בתמונה
המוקד בו לימפוציטים מסוג B
מתחילים את תהליך הדיפרנציאציה והפרוליפרציה שלהם

Germinal center מהו
מסומן במס 2 בתמונה

Lympth nodule המרכז הבהיר ב
המוקד בו לימפוציטים מסוג B
מתחילים את תהליך הדיפרנציאציה והפרוליפרציה שלהם

B מה קורה במצב רגיל ללימפוציטים מסוג?
(רמת פעילות, צבע, אופי התא)
לא משופעלים,
הגרעין שלהם תופס את רוב התא
כהים
מהם תאי פלסמה?
תאים מסוג לימפוציטים B
במצב של שיא השפעול- בהירים, הרבה ציטופלזמה (לעומת תאים במצב שאינו השפעול)
איך קוראים למבנה ההסטולוגי המסומן במס 3?

Corona
Germinal center מסביב ל
(CAP אם האיזור לא יקיף את כל הזקיק הוא ייקרא)
Corona מהו המבנה ההיסטולוגי ?
מבנה ההסטולוגי המסומן במס 3
Germinal center מסביב ל
(CAP אם האיזור לא יקיף את כל הזקיק הוא ייקרא)

מה בתמונה?

lymphatic node
קשר לימפה
Lymph node מה התפקיד של ה?

לסנן את נוזל הלימפה
הנוזלים מגיעים במקור מרקמות הגוף, חלקם חוזרים ללב ע”י מערכת ניקוז ורידית, וחלקם חוזרים דרך המערכת הלימפטית.